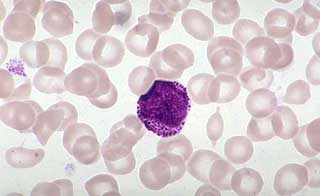
миелоциты

Описание этих клеток
Миелоциты — это незрелые гранулоциты, которые образуются в костном мозге.
Со временем из них начинают выделяться метамиелоциты, которые впоследствии превращаются в зрелые клетки. Размеры миелоцитов колеблются в пределах 12-20 мкм, и они имеют сегментированное ядро.
Эти клетки крови присутствуют исключительно в костном мозге.
Поэтому их нельзя обнаружить в периферической крови. Если же миелоциты появляются в анализах, это может свидетельствовать о наличии различных патологий, сопровождающихся лейкоцитозом.
Важно отметить, что процесс кроветворения невозможен без незрелых клеток. Эта система достаточно сложна и функционирует подобно часам.
Формирование всех типов кровяных клеток происходит в строго отведенное время. Лишь после полного созревания клетки попадают в кровеносную систему организма.
Миелоциты в крови являются важным показателем, который может свидетельствовать о различных состояниях организма. Врачи отмечают, что наличие миелоцитов, незрелых клеток крови, в периферическом кровотоке обычно указывает на активное кроветворение в костном мозге. Это может происходить в ответ на инфекцию, воспаление или другие патологические процессы. Врачам важно учитывать, что миелоциты могут быть признаком серьезных заболеваний, таких как лейкемия или миелодиспластический синдром. Поэтому при обнаружении этих клеток в анализах необходимо провести дополнительные исследования для уточнения диагноза и определения дальнейшей тактики лечения. В целом, миелоциты служат важным маркером, который помогает врачам в диагностике и мониторинге состояния пациента.
https://youtube.com/watch?v=SRjVEnUIsdA
Классификация
Существует три типа миелоцитов:
- Эозинофильные. Эти клетки обладают слабобазофильной протоплазмой, насыщенной крупными гранулами, и окрашены в розово-красные тона.
- Нейтрофильные. Молодые клетки имеют розово-фиолетовый цвет, в то время как зрелые характеризуются протоплазмой розового оттенка. Их гранулы могут быть как мелкими, так и более крупными.
- Базофильные. Эти клетки имеют оксифильную протоплазму и фиолетовые гранулы.
По завершении процесса созревания все три типа клеток трансформируются в сегментоядерные лейкоциты.
| Параметр | Значение в норме (в % от общего числа лейкоцитов) | Возможные причины повышения |
|---|---|---|
| Миелоциты | 0-1% | Инфекции (бактериальные, вирусные), воспаления, лейкозы, опухоли, воздействие токсинов, после химиотерапии |
| Соотношение миелоцитов и других клеток миелоидного ряда | Низкое | Нормальное кроветворение |
| Клиническая значимость | Повышение указывает на сдвиг влево в лейкоцитарной формуле, свидетельствующий о реакции костного мозга на инфекцию или другое заболевание. | Необходимо учитывать в комплексе с другими показателями крови и клинической картиной. |
Норма, в том числе при беременности
В нормальных условиях миелоциты не обнаруживаются в крови как у взрослых, так и у детей. В костном мозге их содержание должно оставаться в пределах 8-15 процентов. Нормальные значения для различных типов клеток представлены в таблице ниже.
| Наименование | Нормальные количественные показатели, % |
| Нейтрофилы | 4.8 — 9.6 |
| Эозинофилы | 0.6 — 2 |
| Базофилы | 0.2 — 1 |
Указанные уровни не являются признаком патологии.
Как правило, показатели у мужчин аналогичны тем, что наблюдаются у женщин.
У новорожденных в крови может присутствовать до 0.5 процентов незрелых гранулоцитов, которые в течение короткого времени исчезают при отсутствии каких-либо отклонений в здоровье.
У женщин в период беременности нормальное содержание миелоцитов не должно превышать трех процентов. Если в ходе лабораторного анализа были обнаружены эти клетки, врачами рекомендуется повторное исследование, а затем проводить его каждые семь дней.
Также стоит подчеркнуть, что небольшое превышение нормальных показателей не оказывает негативного влияния на здоровье будущего ребенка.
Во время беременности наличие незрелых клеток может свидетельствовать о простудных заболеваниях или воспалительных процессах в горле.
Миелоциты — это незрелые клетки, которые обычно не встречаются в периферической крови здорового человека. Их наличие может свидетельствовать о различных заболеваниях, особенно связанных с кроветворением. Многие люди, узнав о миелоцитах в анализах, начинают беспокоиться, так как это может указывать на серьезные проблемы, такие как лейкемия или другие виды рака крови. Однако важно помнить, что наличие миелоцитов не всегда означает наличие болезни. В некоторых случаях они могут появляться при острых инфекциях или стрессовых состояниях. Врачи подчеркивают, что для точной диагностики необходимо учитывать весь контекст: симптомы, другие показатели крови и результаты дополнительных исследований. Поэтому при обнаружении миелоцитов в анализах важно не паниковать, а обратиться к специалисту для получения квалифицированной помощи и рекомендаций.
https://youtube.com/watch?v=aN5D1kYLkQE
Как обозначаются в анализах
Для определения количества миелоцитов специалисты используют лейкоцитарную формулу. Если в образце присутствуют незрелые клетки, лейкограмма смещается влево. В анализе это обозначается как Mie.
Причины появления, и что означает повышение значения
Наличие незрелых клеток крови в циркулирующей крови может указывать на наличие воспалительного процесса в организме человека.
https://youtube.com/watch?v=tEll-mUFPYU
У взрослых
Существует множество факторов, способствующих повышению показателей.
К наиболее распространённым из них можно отнести:
- инфекционные заболевания вирусного и бактериального происхождения;
- острый пиелонефрит;
- воспаление аппендикса;
- сильная интоксикация, например, при отравлении алкоголем, тяжелыми металлами или химическими веществами;
- некроз тканей, возникающий при инфаркте или инсульте, а также гангрена и обширные ожоги;
- онкологические болезни в стадии распада злокачественных образований;
- паратиф;
- грипп или корь;
- брюшной тиф;
- лейкоз;
- краснуха;
- анемия, вызванная нехваткой витамина В12;
- лучевая болезнь;
- длительное облучение в процессе химиотерапии или радиотерапии;
- злокачественные заболевания крови;
- апластическая анемия.
Кроме того, повышенные миелоциты могут возникать на фоне:
- острых кровотечений;
- коматозных состояний;
- нарушений кислотно-щелочного баланса;
- шока;
- чрезмерных физических нагрузок.
Нередко незрелые клетки появляются в результате продолжительного применения некоторых медикаментов, таких как обезболивающие средства или иммунодепрессанты.
В детском возрасте
Миелоциты у детей могут возникать по следующим причинам:
- врожденные сердечные аномалии;
- ацидоз и ангина;
- серьезные отравления медикаментами или свинцом, что приводит к нарушению работы костного мозга;
- пневмония;
- туберкулез;
- интоксикация ядовитыми веществами, выделяемыми патогенными микроорганизмами;
- заболевания органов пищеварительной системы;
- сильная рвота;
- обезвоживание;
- злокачественные новообразования;
- метастазы, проникающие в костный мозг.
В таких случаях дополнительные обследования проводятся без промедления, что помогает защитить иммунную систему ребенка от серьезных нарушений. Появление незрелых клеток в крови представляет собой значительную угрозу для детского организма, так как на фоне воспалительных процессов могут развиваться более тяжелые состояния.
У беременных
Как было отмечено ранее, миелоциты могут встречаться в крови у женщин в положении. Это связано с тем, что в процессе беременности лейкоциты вырабатываются активнее, что приводит к их попаданию в кровяное русло. В этот период допустимый уровень не должен превышать 3 процентов.
Тем не менее, стоит помнить, что даже небольшое количество незрелых клеток может свидетельствовать о наличии проблем в организме будущей матери, таких как воспалительные процессы в горле.
Методы лечения
Для снижения уровня миелоцитов в крови в первую очередь необходимо выяснить причину, вызвавшую данное состояние.
Чаще всего это происходит из-за инфекционного агента, что может привести к образованию гнойных очагов или воспалительных процессов.
На сегодняшний день не существует лекарства, которое могло бы непосредственно устранить появление миелоцитов в плазме. Необходим комплексный подход к лечению.
Если причиной является инфекционное заболевание, основным методом терапии становится применение антибиотиков.
При выраженном течении болезни врач может назначить противовоспалительные препараты, содержащие гормоны. Для облегчения сопутствующих симптомов могут быть рекомендованы дополнительные медикаменты.
В случае сильной интоксикации принимаются меры по ее устранению, а также исключается контакт с раздражающими факторами.
Далее применяются средства, способствующие восстановлению питания тканей и укреплению иммунной системы пациента. В качестве дополнительных мер могут быть рекомендованы биологически активные добавки.
Иногда достаточно изменить рацион, добавив в него продукты, богатые витаминами А, С и группы В.
Следует избегать употребления консервантов, копченостей и жирной пищи.
Сбалансированное питание помогает укрепить иммунитет, который сможет эффективно бороться с патогенными микроорганизмами.
Миелоциты играют важную роль в организме человека и находятся в костном мозге. В норме их не должно быть в крови.
Наличие незрелых клеток указывает на наличие заболевания. Только при своевременном начале лечения можно нормализовать миелоидные показатели и улучшить состояние пациента.
Вопрос-ответ
Почему в крови появляются миелоциты?
Значительное омоложение клеток (в крови отмечается присутствие метамиелоцитов, миелоцитов, промиелоцитов, бластных клеток) может указывать на хронические лейкозы, эритролейкоз, миелофиброз, метастазы злокачественных новообразований, острые лейкозы. В таких случаях принято говорить о лейкемоидной реакции.
Сколько должно быть миелоцитов в крови?
В норме миелоциты и метамиелоциты в крови должны отсутствовать. Сегментоядерных нейтрофилов должно быть 47-72% от общего числа лейкоцитов, палочкоядерных – 1-6%.
Что в анализе крови должно насторожить?
В анализе крови насторожить могут такие показатели, как повышенный уровень лейкоцитов (может указывать на инфекцию или воспаление), низкий уровень гемоглобина (анемия), повышенные показатели печеночных ферментов (проблемы с печенью), а также аномальные уровни электролитов и сахара в крови. Также стоит обратить внимание на изменения в тромбоцитах и соотношении различных типов лейкоцитов.
Когда появляются метамиелоциты?
Клетки более ранних этапов созревания (метамиелоциты, миелоциты и другие) могут появляться в мазке крови в исключительных случаях – например, при тяжелых инфекционных заболеваниях, когда костный мозг выбрасывает на борьбу с инфекцией еще не созревшие клетки (это называется сдвигом лейкоцитарной формулы влево).
Советы
СОВЕТ №1
Обязательно проконсультируйтесь с врачом, если в анализах крови обнаружены миелоциты. Это может быть признаком различных заболеваний, и только специалист сможет правильно интерпретировать результаты и назначить необходимое лечение.
СОВЕТ №2
Следите за своим общим состоянием здоровья и обращайте внимание на любые изменения, такие как усталость, слабость или частые инфекции. Эти симптомы могут быть связаны с изменениями в составе крови и требуют медицинского внимания.
СОВЕТ №3
Регулярно проходите медицинские обследования и анализы крови, особенно если у вас есть предрасположенность к заболеваниям крови или другие хронические заболевания. Это поможет своевременно выявить возможные отклонения и принять меры.